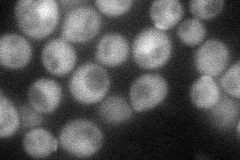
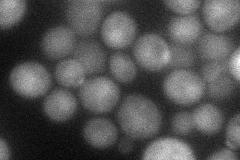
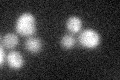

View description
F-box protein component of the SCF ubiquitin-ligase complex; involved in carbon catabolite repression, glucose-dependent divalent cation transport, high-affinity glucose transport, morphogenesis, and sulfite detoxification
Localization:
Intensity:
Fold change:
Significance:
-
C’ GFP library in SD

below threshold16.38 -
N' NOP1pr-GFP in SD
cytosol,bud neck49.9413 -
N' TEF2pr-mCherry in SD
punctate,bud,nucleus41.2705 -
N' NATIVEpr-GFP in SD

below threshold25.8643 -
N' TEF2pr-VC and Cyto-VN in SD

#N/A0 -
C’ GFP library in SD+DTT
cytosol15.790.96No -
C’ GFP library in SD+H2O2

cytosol20.361.24No -
C’ GFP library in Starvation Media

cytosol15.820.96No -
C’ GFP library on the background of Pup2-DaMP

below threshold -
C’ GFP library on the background of CCT mutant

below threshold18.27941.1151No
